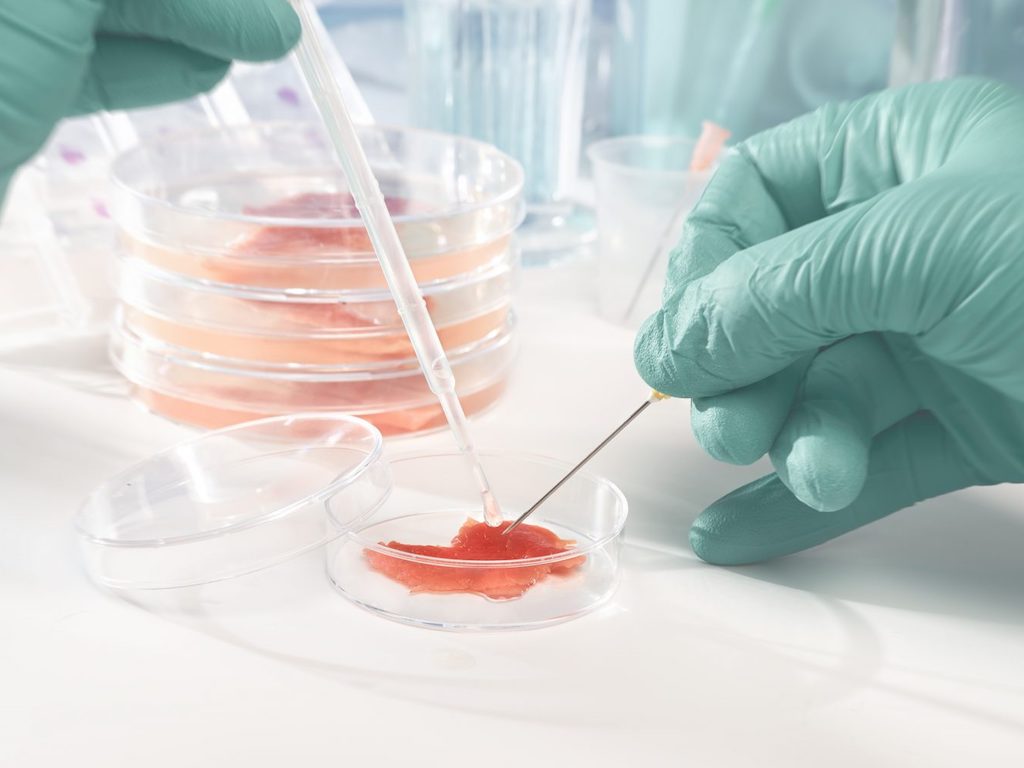

TurtleTree Scientific, the new venture dedicated to food-grade growth factors launched by Singapore cell-based milk startup TurtleTree Labs, has just announced a strategic partnership with biotech leader Dyadic International to develop a range of recombinant proteins growth factors that can be produced at high-yields and for a low-cost. TurtleTree says that this could mean not only expediting the path to market for cultivated food techs, but crucially will significantly slash prices to “make cellular agriculture a reality for all.”
Announced today (February 2), TurtleTree Scientific and Dyadic, the biotech behind the C1 gene expression platform used by the likes of DuPont, BASF and Abengoa, will be working together to develop a number of recombinant proteins growth factors. The fully funded collaboration will see the two firms produce these food-grade growth factors at high-yields and for low-cost in bioreactors, helping to overcome one of the key cost obstacles the cultivated protein industry faces with regard to scaling up for commercialisation.
Currently, growth factors and cell culture media take up anywhere between 55-95% of the marginal cost in manufacturing cell-based foods.
“This catapults TurtleTree Scientific to a global market leader in food grade growth factors at a price point that will make cellular agriculture a reality for all,” commented TurtleTree co-founder and chief strategist Max Rye.

It was important for us to partner with Dyadic and C1 to help us overcome this hurdle, without compromising on the safety or efficacy of these growth factors while lowering our capital and operating expenditures.
Max Rye, Co-Founder & Chief Strategist, TurtleTree Labs
Dyadic’s hyper-productive fungal expression system is validated at a scale of 500,000 litres. The new advanced C1 strains are GRAS-certified food-grade quality, which would help expedite the regulatory process for cell-based firms to get their products to market.
“It has been a challenge to manufacture human growth factors at a large scale at an affordable cost, in order to enable several exciting commercial processes we are targeting. It was important for us to partner with Dyadic and C1 to help us overcome this hurdle, without compromising on the safety or efficacy of these growth factors while lowering our capital and operating expenditures,” Rye continued.
In conversation with Green Queen Media, Rye said that the commercial agreement with Dyadic has been months in the making, and that TurtleTree is now already in talks to work with a number of undisclosed cell-based meat companies who will use these growth factors provided by Dyadic’s industry-proven technology to accelerate the development of their cultivated products and go-to-market strategies.

Crucially, this would also enable food techs to slash the price of production so much that cell-based meat could be sold to consumers “at price parity with what you can find in supermarkets today,” explained Rye.
This catapults TurtleTree Scientific to a global market leader in food grade growth factors at a price point that will make cellular agriculture a reality for all.
Max Rye, Co-Founder & Chief Strategist, TurtleTree Labs
In a statement about the new partnership, Dyadic’s vice president of research and business development Ronen Tchelet, PhD. said: “We are very excited to have the opportunity to work with TurtleTree as they position themselves as innovators of novel human growth factors by applying synthetic biology to engineer C1 cells to speed up the development and help lower the cost of a growing number of biological processes and products.”
Rye further told Green Queen Media that another big issue that cultivated protein companies face is on the regulatory side, and being headquartered in Singapore, where regulators gave the world’s first approval for cultured protein, is the “perfect place” for food techs to tap into TurtleTree’s growth factor platform given the existing pool of customers and demand for scale up.
Lead image courtesy of Shutterstock.